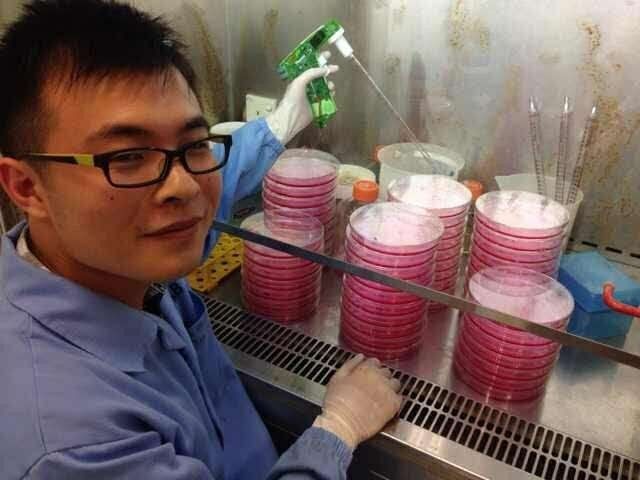
d1f8e63131b5feda0c5a98fecdf7aa32.jpeg

狮城学子风采|生物汪读博二三事

新加坡学联 | 所有留学新加坡学者学生最应该关注的公众号
习近平总书记在十九大报告中提出,“青年兴则国家兴,青年强则国家强。青年一代有理想、有本领、有担当,国家就有前途,民族就有希望。中国梦是我们这一代的,更是青年一代的。”
新加坡学联特推出“狮城自学子风采”栏目,邀请了一批国家优秀自费留学生奖学金获得者与大家分享在人生成长、留学生活、科研经历等方面的心得,引领广大青年坚定理想信念,志存高远,脚踏实地,勇做时代的弄潮儿,在实现中国梦的生动实践中放飞青春梦想,在为人民利益的不懈奋斗中书写人生华章!
于涛,一位谦虚、幽默、随和的生物学研究者。此时此地,他为我们带来了一些科研路上的感悟:
写这篇经验的时候,正值自己在临近毕业的选择中,也算是好好总结一下这个章节。如果能给新来的小鲜肉们带来一些积极的影响,或者是启发了一些思考,便是锦上添花了。
我所期待的学术圈
读博之前,我一直觉得做学术就安心做学术,有正常的学术交流是必须的,但顺其自然就可以,没有必要刻意去建立一些关系和人脉。
回想起来,之所以有这样的认识,源头在于过分唯物主义的认知体系。对应到学术上,就是以为学术成果本身的绝对价值是不可撼动的,并且不随着推广方式和人脉关系而改变。但很显然,这并不是世界本来的面貌。即使是放在特别长的时间维度上,也只有少数有特别高的绝对价值的东西是符合这样的唯物主义的,比如屠呦呦的青蒿素。
更多更多的情况,你所研究的东西,需要你努力去推广,而建立必要的人脉关系,尤其是能够让圈子里面比较有代表性的人物知道你在做什么,是非常有意义的事情。虽然这与我所期待的学术圈有点不太一样,但总的来说推广自己的研究成果本身并不让人厌烦,或者从某种角度来说,应该渐渐喜欢这个过程,如果真的觉得自己做的东西好的话。
付出与收获
貌似经过这几年媒体中社会论调的改变,很多人也都开始接受了付出不一定有收获的现实。作为一个生物狗,对此体会尤其深刻。
有小伙伴就会说了,你已经收获不少了吧,还出来说这个,装不装。那其实是你没看到付出和回报不成正比的地方。如果我前两年每个星期工作超过80个小时,其实这样的收获也不是很多对不对。毕竟一篇cell也就是个co-first,毕竟自费留学生奖也不能承诺一个好的博后的位置。
那与此相对应的一个论点就是,如果你不付出的话,就一定没有收获,即付出给你带来的是收获的希望。又有一个进一步的论点就是拉长时间维度的话,你付出的东西,可能在未来的某个时间给你带来回报。
与此并行的一个论点是即使没有获得期待的收获,但你的付出对你产生的潜移默化的影响,让你更加成熟自信。
总得来说,这碗鸡汤就是你得保持一个好的态度,不能因噎废食。
昨天某著名教授跟我说,他感觉在学术圈成为PI的人,不是靠多么才华横溢,多么埋头苦干,而是总是失败,却还愿意努力去迎来那一次成功的喜悦,是这样一种态度。
专业
这段并不是要写要选什么专业,想说的是professional的意思。这也许是我整个读博期间最重要的收获。
不太清楚其他人是什么样子,我来新加坡之前的感触是,见过的实验室里面的人,或多或少都会在工作时间偷偷做一些明目张胆的闲事,比如打个游戏,看个视频,诸如此类。并且可能还有理由,比如自己每天晚上十一点才离开实验室,只是把自己休闲的时间稍微提前了一点,没什么大不了。来了新加坡之后的体会是,新加坡人特别在意工作时间的工作态度,即你是不是professional。比较简单的理解就是,当你玩的时候,会影响周围同事的工作热情,因此老板特别在意。对于个人而言,其实能够特别自制的人还是比较少的,如果不利用这种外部给予的规则去保证工作时间的效率的话,等到了没人管的下班时间,不是很多人能保证那种时间的工作效率。
这也可以算是一种态度,或者把它当成约束自己的工具,在工作时间,只做与工作相关的事。
遗憾
总结自己的时候,一个最重要的问题往往是自己还有什么本可以做得更好的地方。倘若是某一个具体的选择的话,有时候会觉得自己总结得没有上升到本质。倘若真的抽出其中的本质,有时候又会发现自己一些丑恶并难以改变的点。虽然工作时间很长,但可能精神上是懒惰的。虽然坦然接受了自己没有收获的,但可能内心还是贪婪的。
读博之后,我就开始对这样的总结产生怀疑。我们学习历史的话,可以去找共性,所以有助于归纳有利与有害。我们审视自己,永远只是个例,这件事情好像只有在产生一个目标之后才有意义,因为为了达成目标,我们可以学习需要些什么,在这样的前提下去挖掘自己以前的一些优势和劣势,并试图调整。
我现在的目标是找博后,这样总结起来的话,可能没有建立比较广的人脉算是一个遗憾吧。这个问题的另一半要坐落在感情上,便又是一个完全不同的讨论,也与本文主题无关了。
历史就是一个循环,该走的弯路,你们还是得走,我不希望也不认为本文可以帮谁少走弯路。但如果你有了一些进一步的思考,也许你会更能理解和享受这个过程,即使有时是弯路。
据说还要写个人生格言,这种东西一直在变,而且总觉得找不到一句合适的来概括自己想表达的全部。
写到这,突然就放一个:
一直在变。
当作随意的格言好了。
获奖者的自我介绍
姓名于涛,性别男,2012年中国科学技术大学生命科学本科毕业,Gap一年,2013年开始在新加坡国立大学攻读理学博士学位,如果答辩顺利的话将于2017年底毕业。研究课题对于非本专业人士比较不太友善—SUMO化抑制内源反转录病毒的机制研究。翻译一下大概就是我们的DNA里面有一部分其实来自于病毒,在发育过程中,需要抑制它们的活性,我们发现有一种蛋白质的修饰就是所谓的SUMO化可以抑制这些病毒,于是展开了进一步的原理的研究。(翻译完了估计还是不太通俗,反正我爸妈还听不懂=。=)博士期间得过国家自费留学生奖学金这个奖,发过一篇Cell和一篇review,做过两次学术报告,其中一次得了最佳短报告的小奖。
(获奖者备注:好像写得一点也不正式,因为酝酿了一下写经验交流的情绪,瞬间口语化了。)
长按图中鱼尾狮,识别二维码
关注新加坡中国学者学生联合会官方微信
获取更多资讯

评论